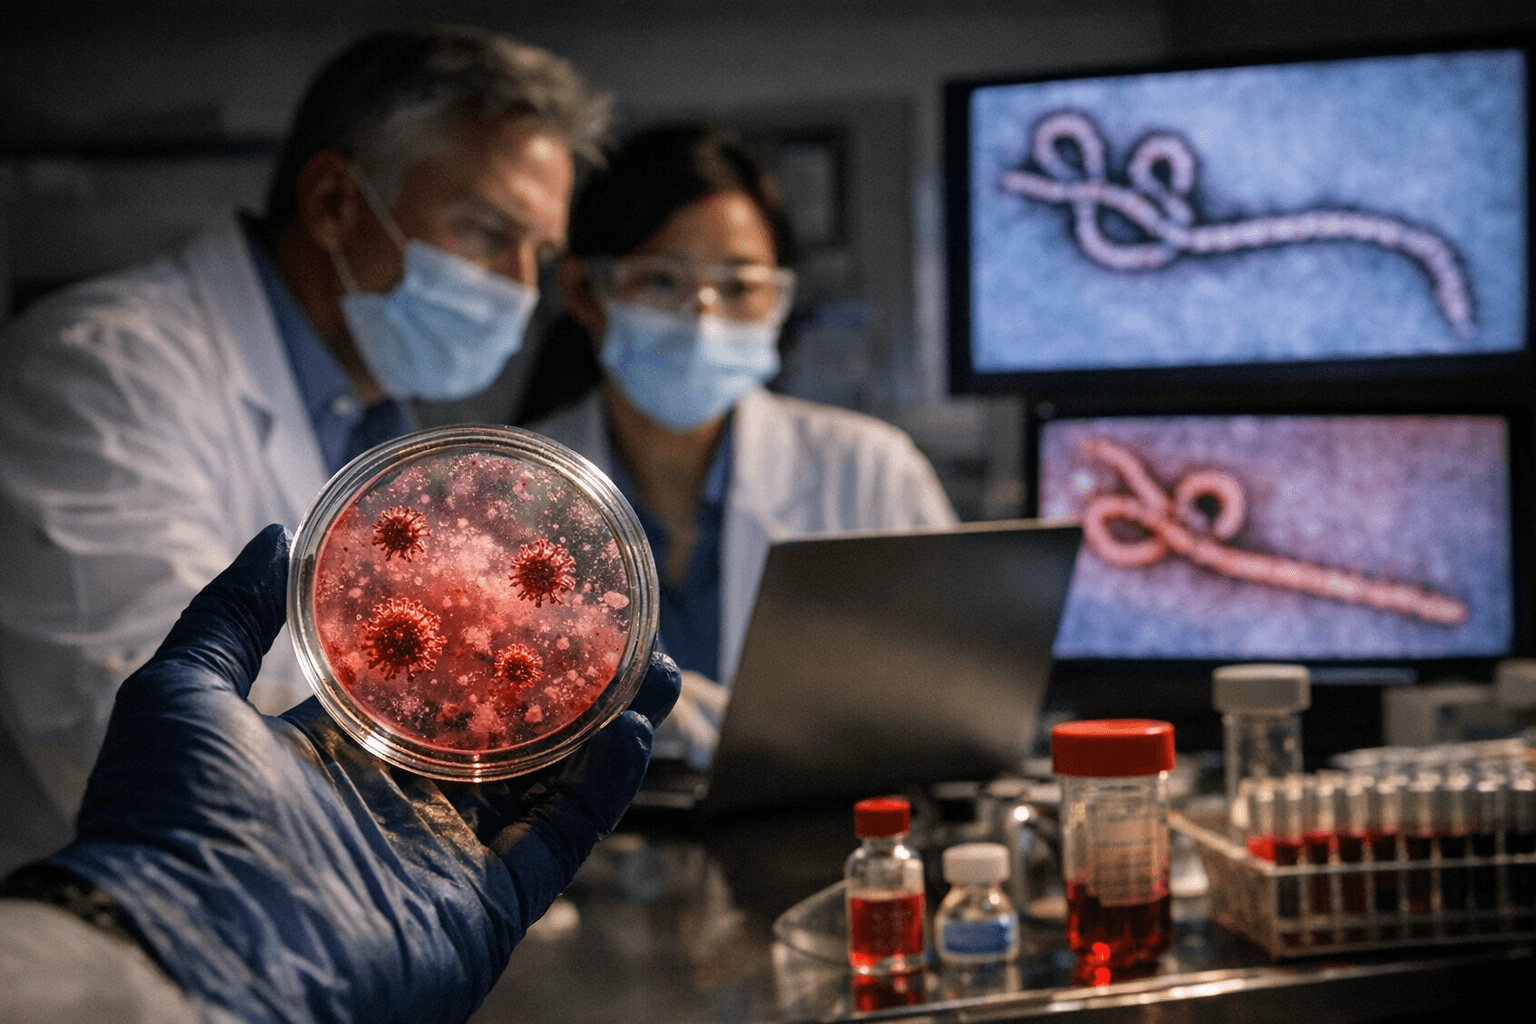
Okogen Acquires Ranpirnase Assets from Orgenesis to Expand Antiviral Pipeline

Okogen Acquires Ranpirnase Assets from Orgenesis to Expand Antiviral Pipeline
Okogen acquired ranpirnase's global IP from Orgenesis, targeting pink eye, Marburg virus, and RSV with a drug that showed preclinical activity against Ebola and HIV.
Ranpirnase, a broad-spectrum antiviral compound with preclinical activity against HIV, Ebola, SARS, and HPV, changed hands again on March 26 when Plano, Texas-based Okogen Inc. acquired its global intellectual property portfolio and development assets from Orgenesis Inc. (OTC: ORGS), positioning the molecule at the center of an ambitious four-pillar pipeline that stretches from pink eye treatment to potential biodefense against Marburg and Sudan viruses.
The acquisition anchors Okogen's lead program, OKG-0303, an investigational therapy for acute infectious conjunctivitis. The company describes the conjunctivitis market as one where treatment "remains fragmented with no single therapy addressing both viral and bacterial causes," a gap OKG-0303 is designed to close. Beyond ophthalmology, Okogen is organizing its ranpirnase work into what it calls the Ranpirnase Platform, with development pillars spanning eyecare, systemic infectious disease, dermatology, and medical countermeasures for high-consequence pathogens including filoviruses. The company said it is engaging with U.S. and international government agencies to evaluate ranpirnase's role against Marburg and Sudan viruses specifically, while running parallel research into influenza and RSV.
Ranpirnase has traveled a winding ownership path to reach Okogen. Orgenesis first acquired the compound in April 2020 as part of its purchase of assets from Tamir Biotechnology Inc., which had built ranpirnase into what it described as a broad-spectrum antiviral platform. That transaction was valued at approximately $19 million in stock and cash, according to the Orgenesis announcement at the time, though Contract Pharma reported the total consideration at approximately $16.8 million. Orgenesis never resolved that discrepancy publicly in available statements, noting its $19 million figure was "based on the value of the stock at closing."
TamirBio President Jamie Sulley framed the compound's potential in 2020, stating that ranpirnase "has already demonstrated preclinical antiviral activity in such viral diseases as HPV, HIV, Ebola, and SARS." TamirBio had also advanced the compound into a Phase I/II clinical trial evaluating topical ranpirnase against genital warts caused by HPV, the worldwide leading cause of that condition, and Sulley noted the study "demonstrated the clear clinical effect of ranpirnase." Under Orgenesis, the plan had been to combine ranpirnase with Bioxome technology, a proprietary delivery platform designed to fuse with cell membranes and shuttle therapeutic cargo directly into cells in a manner mimicking natural exosomes. Orgenesis CEO Vered Caplan said at the time that the combination "could result in an enhanced payload delivery into cells." Whether Okogen intends to pursue that delivery approach as part of the acquired assets has not been disclosed.
No financial terms for the Okogen-Orgenesis transaction were disclosed in the March 26 announcement. The deal transfers the global intellectual property portfolio and development assets but Okogen has not detailed the specific patents, regulatory filings, or clinical data packages included in the transfer. The company's stated near-term priority is rapid advancement of OKG-0303 through development, with the government biodefense and respiratory programs running in parallel.
Sources:
Know something we missed? Have a correction or additional information?
Submit a Tip

